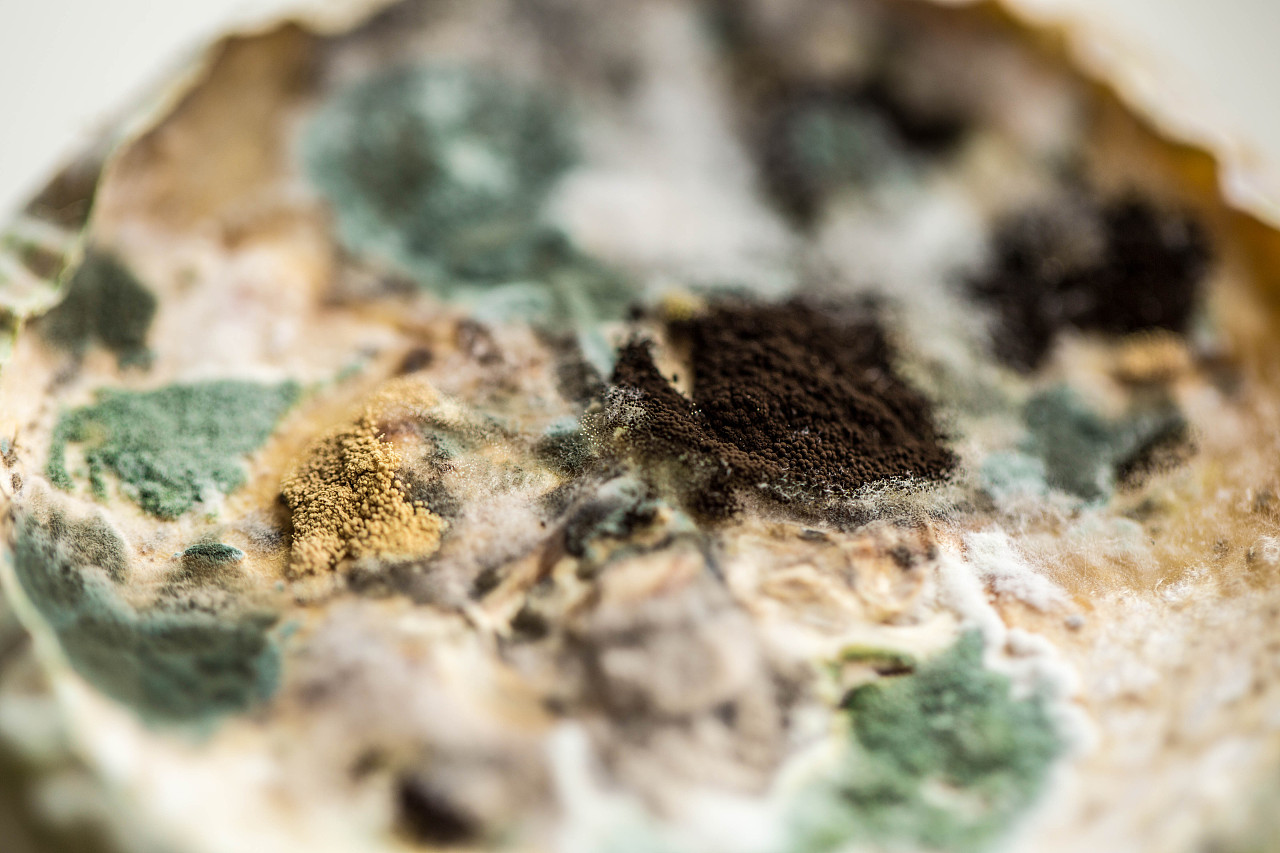
霉菌mould

腐霉菌图片

针对食品厂霉菌又有几种消毒走下神坛
图片尺寸800x468
发霉图片
图片尺寸525x350
除了细菌,如何预防和去除家中的霉菌,避免生病?
图片尺寸600x408
微世界看农业/亮盾 利农/农业的福音/ - 抖音
图片尺寸1920x1900
在腐烂的食物表面的不同颜色的霉菌
图片尺寸800x533
近距离观察植物中白色发霉,菌类,果实上滋生霉菌,腐烂产品和生命.
图片尺寸1200x800
霉菌繁殖迅速,常造成食品及用具等大量霉腐变质.
图片尺寸622x474
德巴利腐霉
图片尺寸534x400
什么因素促使面包霉菌生长最快?
图片尺寸640x427
霉菌其他生物学相关
图片尺寸800x600
揭秘超级致癌物:黄曲霉菌,你身边的潜在健康威胁!
图片尺寸640x960
霉菌mould
图片尺寸1280x853
霉菌是什么预防霉菌污染食品的措施
图片尺寸800x320
霉菌mould
图片尺寸1280x853
农作物苦瓜,连续下雨后长霉菌,大家帮忙看下这是什么霉菌,应该用什么
图片尺寸1080x1456
腐烂_全景网
图片尺寸600x399
霉菌mould
图片尺寸1280x853
霉菌是一种常见的微生物,它可以在潮湿,温暖的环境中繁殖生长,对人体
图片尺寸640x425
霉菌大 揭秘
图片尺寸2000x2667
一次由腐乳而产生的霉菌学习
图片尺寸1200x900